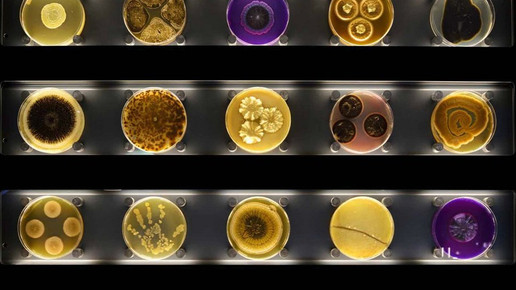
micropia10 micropia

Niederlande
Micropia, der Mikrobenzoo
Berlin
-
Der weltweit erste Mikrobenzoo „Micropia“ im Amsterdamer Zoo macht Mikroben für Laien sichtbar. Die niederländische Königin Máxima eröffnete die Ausstellung.
Mikroben können die Probleme der Erde lösen, sagt Haig Balian. Seit 2003 ist er Direktor des Amsterdamer Artis, dem nach eigenen Angaben ältesten Zoo der Welt, der 1838 seine Türen öffnete. Mikroorganismen, rund zwei Drittel aller lebenden Arten auf der Welt, machen ein Leben erst möglich. In „Micropia“, dem weltweit ersten „Mikrobenzoo“, werden sie jetzt auch für Laien sichtbar gemacht.
Archivbeitrag vom 5. Oktober 2014
Weitere Empfehlungen: